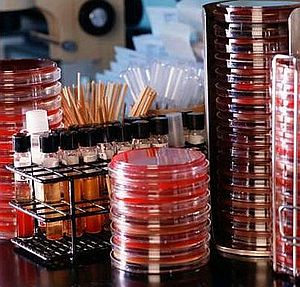

Что такое STEM-терапия?
Процесс лечения такими клеткам разделён на несколько этапов:
- На первом выполняются медицинские процедуры с применением плазмафереза, копаксона и других веществ — в зависимости от рассеянного склероза, спецификации недуга и других факторов. Главная задача на первом этапе процедур — приостановить процесс разрушения миелина и купировать иммуно-воспалительный процесс.
- На втором, третьем, а при необходимости и на четвертом этапе лечения склероза выполняется пересадка стволовых клеток. Это собственные мезенхимальные стволовые клетки, выделенные из биоматериала пациента — костного мозга и жировой ткани.
Операции по пересадке при рассеянном склерозе осуществляют с перерывом в 30 дней. Обычно в ходе одной процедуры в кровь пациента вводятся клетки в количестве из расчета 1 миллион на 1 килограмм тела пациента (например, для пациентов с массой тела 70 кг необходимо интеграция 70 миллионов клеток). Уже в течение небольшого времени организм больного показывает первые признаки улучшения, связанные со стабилизацией приема и передачи нервных сигналов и восполнения популяции нейронов.
- Спустя 1,5-2 месяца улучшается функция вестибулярного аппарата, восстанавливается чувствительности, психологическое состояние приходит в норму.
- В течение 3-4 месяцев восстанавливается походка, возвращается память, пропадает раздвоение в глазах.
- В течение 10 месяцев прекращается зарождение новых зон демиелинизации и появление новых рубцов.
При этом:
- Наступает стойкая ремиссия.
- Психологическое состояние стабилизируется, возвращается память, исчезают симптомы хронической усталости.
- Полностью обновляется работа речевого аппарата.
ВНИМАНИЕ! При соблюдении рекомендаций доктора, терапевтический эффект может сохраняться длительное время, предоставляя возможность жить в социуме
Врачи, занимающиеся лечением рассеянного склероза, все чаще обсуждают перспективы применения стволовых клеток. Многие специалисты отмечают, что эта терапия может стать прорывом в борьбе с заболеванием, поскольку стволовые клетки обладают способностью восстанавливать поврежденные нервные ткани и модулировать иммунный ответ. Однако, несмотря на обнадеживающие результаты первых клинических испытаний, врачи подчеркивают, что необходимо больше исследований для оценки долгосрочной эффективности и безопасности такого подхода. Некоторые эксперты выражают осторожность, указывая на возможные риски и осложнения, связанные с процедурой. В целом, мнения врачей разделяются: одни видят в стволовых клетках надежду на улучшение качества жизни пациентов, другие призывают к более тщательному изучению и соблюдению этических норм.
Читаем
-
В настоящее время все шире используются физические методы лечения при заболеваниях, ранее считавшихся противопоказанием к назначению физиотерапевтического лечения: в онкологии, кардиологии, при туберкулезе, а также при инфекционных заболеваниях.
-
Кроме того, что селезенка выступает в качестве системы фильтрации для красных кровяных телец (эритроцитов), она играет очень важную роль в поддержании иммунной системы организма и борьбе с инфекциями.
-
Угри влияют на состояние кожи большинства подростков и значительное количество взрослых. Некоторым людям повезло и они у них бывают лишь в единичных случаях, в то время как другие могут испытывать постоянные проблемы.
-
Для того, чтобы ускорить процесс заживления после хирургических процедур на деснах, уже сегодня стоматологические центры предлагают самые передовые технологии — лечение обогащенными тромбоцитами.
-
Самая главная рекомендация — подбирайте оральный контрацептив (ОК) с врачом-гинекологом и читайте инструкцию по применению препарата. Здесь же собраны общие сведения и правила забытых таблеток.
Лечимся
-
УВЧ-терапия (ультравысокочастотная терапия) — метод электролечения, при котором воздействие на определенный участок тела больного происходит непрерывным или импульсным электрическим полем ультравысокой частоты.
-
Лазерная хирургия шейки матки — это термическое, дозированное на строго определенной глубине воздействие лазерного луча при лечении гинекологических заболеваний.
-
ТУР (трансуретральная резекция) предстательной железы — удаление части простаты, суживающей мочеиспускательный канал.
-
Процедура удаления лазером образования или родинки сопровождается испарением их клеток до полного выравнивания поверхности кожи. Луч лазера полностью контролируем, поэтому соседние участки ткани не успевают нагреться и не происходит их ожога.
-
Механотерапия — выполнение дозированных движений с помощью специальных аппаратов пассивного или активного действия.
Лечение рассеянного склероза стволовыми клетками вызывает множество обсуждений и мнений среди пациентов и специалистов. Многие пациенты, прошедшие через эту терапию, отмечают значительное улучшение состояния, уменьшение симптомов и даже восстановление утраченных функций. Однако не все так однозначно: некоторые эксперты подчеркивают, что результаты могут варьироваться, и не всегда возможно достичь желаемого эффекта. Важно также учитывать, что данная методика еще находится на стадии исследования, и долгосрочные последствия лечения остаются недостаточно изученными. Пациенты часто делятся своими историями в социальных сетях, создавая сообщества поддержки, где обсуждают как положительные, так и отрицательные аспекты терапии. В конечном итоге, каждый случай уникален, и решение о лечении должно приниматься совместно с врачом, основываясь на индивидуальных особенностях заболевания и состоянии здоровья.
Лечение стволовыми клетками. Центр биотерапии при Военном Госпитале г. Харбин
Способность стволовых клеток к самообновлению имеет значительный потенциал для регенерации тканей.
Центр биотерапии при Военном Госпитале г. Харбина предоставляет пациентам новейшие подходы безопасного лечения стволовыми клетками следующих неврологических состояний:
- Болезнь двигательных нейронов (Боковой Амиотрофический Склероз-БАС, или болезнь Лу-Герига)
- Врожденная гипоплазия мозжечка
Также есть и другие болезни, подходящие для лечения стволовыми клетками, но эффективность лечения при них неопределенна. Эффект возможен, но не гарантирован.
При процедуре лечения вводятся мезенхимальные стволовые клетки. Мезенхимальные стволовые клетки (CBMSC) получают из донорской пуповинной крови. CBMSC имеют большой потенциал в качестве лечебных единиц, они могут мигрировать по всему мозгу и дифференцируются в нейроны и глиальные клетки. CBMSC также имеют такие преимущества, как транс-дифференциация и активация эндогенных нервно-восстановительных процессов.
Метод введения данных стволовых клеток — внутривенные инъекции, в четыре приема, один прием в неделю. Лечение стволовыми клетками ОБЯЗАТЕЛЬНО должно сопровождаться обычным комплексом реабилитационных мероприятий. В общем курс пребывания пациента получается сроком в 2-3 месяца.
Условия лечения в центральной больнице «Нункэн».Пациент проходит курс лечения стволовыми клетками и реабилитационные мероприятия в стационаре реабилитационного отделения центральной больницы «Нункэн».Пациенту предоставляется отдельная двухместная палата (пациент и сопровождающий).В палате имеется душ, раковина, туалет. Холодильник, телевизор с русским телевещанием. В стационаре горячая вода подается только вечером в течение двух часов, через день. В остальное время горячую воду возможно (круглосуточно) набирать в термос из общего титана в конце коридора этажа. Также на этаже имеется стиральная машина. В больнице есть столовая. Для удобства русских пациентов на первом этаже есть общая большая кухня и выделенное место для приготовления пищи. Это дозволенное и законное место приготовления еды. Разогреть еду можно в палате. Можно взять с собой мультиварку для приготовления еды и индивидуальный минимальный набор посуды (ложка, вилка, нож, кружка, тарелка). На палату предоставляется 2 комплекта постельного белья для пациента и сопровождающего. По причине длительного срока пребывания пациента в реабилитационном отделении — белье не меняют, стирать его нужно самостоятельно.
ЛЕЧЕНИЕ СТВОЛОВЫМИ КЛЕТКАМИ (4 введения в течении месяца) — 60 000 юаней.
Что такое стволовые клетки?
- они неспециализированны — это означает, что они не обладают конечной функцией в организме, в отличие от других, специализированных, клеток, выполняющих те или иные профильные функции, как например клетки мышц;
- они могут делиться и обновляться в течение длительного периода времени — это называется пролиферацией;
- при определенных условиях они способны развиться в клетки со специальными функциями — это называется дифференциацией .Например, стволовые клетки обладают потенциалом дифференцироваться в мышечные клетки сердца, клетки, которые производят инсулин в поджелудочной железе или нервные клетки в головном мозге.
Существуют два основных вида стволовых клеток — эмбриональные стволовые клетки и стволовые клетки взрослого человека.
Эмбриональные стволовые клетки
Как следует из названия, эмбриональные стволовые клетки — клетки развивающегося эмбриона. Эти клетки способны превращаться в клетки всех типов, входящих в состав тканей и органов человеческого тела, таких как сердце, кожу и головной мозг.
Стволовые клетки взрослого человека

Количество стволовых клеток, находящихся в организме взрослого человека значительно меньше, чем в эмбрионе. Стволовые клетки можно обнаружить в некоторых тканях и органах взрослого организма , включая костный мозг, кровь и головной мозг.
Роль стволовых клеток заключается в восстановлении и ремонте клеток, которые были утрачены в результате травмы, болезни или возрастных изменений.
Стволовые клетки взрослого человека более ограничены с точки зрения возможности образовывать специализированные клетки тканей и органов: они обычно генерируют типы клеток ткани, в которой они находятся. Вот некоторые примеры:
- Кровообразующие (кроветворные) стволовые клетки — находятся в костном мозге, в крови, а также в пуповине новорожденных. Они способны дифференцироваться в различные типы клеток крови, включая эритроциты, лейкоциты и тромбоциты.
- Стромальные стволовые клетки — находятся в костном мозге. Они дифференцируются в клетки тканей, включая костную, хрящевую, а также жировые клетки.
- Нервные стволовые клетки — находятся в головном мозге. Нервные стволовые клетки могут «воспроизвести» основные типы клеток головного мозга, в том числе нейроны (нервные клетки) и олигодендроциты (клетки, образующие миелиновую оболочку).
Человек — сложный многоклеточный организм. Каждая клетка в нашем теле, будь то нейрон или миоцит (мышечная клетка), имеет специфическое строение и «заточена» под выполнение строго определенных функций.
Больше она ничего не умеет и, покинув организм, вскоре бы погибла.
Но существуют и неспециализированные клетки — они называются стволовыми. Каждая такая клетка может превратиться в специализированную: иммунную, нервную или иную.
У эмбриона стволовые клетки по-настоящему универсальны. Собственно, они, размножаясь и специализируясь, создают весь организм.
У взрослого человека каждая стволовая клетка привязана к определенной ткани, то есть частично утратила универсальность. Во взрослом организме разные типы стволовых клеток нужны для того, чтобы восстанавливать органы после повреждений и обновлять их по мере «износа».
Рассеянный склероз – тяжелое аутоиммунное заболевание поражающее центральную нервную систему: головной и спинной мозг. По невыясненной причине иммунная система начинает атаковать ткани собственного организма, в частности – миелиновую оболочку, покрывающую нервные волокна.
В результате демиелинизации – потери миелина – нарушаются процессы проведения импульсов по нервным волокнам. Функциональная нервная ткань постепенно разрушается и заменяется склеротическими бляшками.
У некоторых пациентов болезнь прогрессирует быстрыми темпами, у других периоды обострений сменяются ремиссиями, когда симптомы ослабевают, или даже улучшениями состояния.
Мы уже упоминали о методе лечения химиотерапией. Расскажем о процессе подробнее.
При помощи стандартной процедуры химиотерапии поражалась иммунная система пациента, что в конечном итоге замедляло разрушительные атаки на нервные клетки организма.
Стволовые клетки получают из костного мозга пациента, а затем вводят их в кровоток. Так называемые гемопоэтические стволовые клетки имеют способность дифференцироваться со всеми клетками крови и имеют огромный восстановительный потенциал.
https://youtube.com/watch?v=AIeVB8DC9xw
С течением времени они постепенно восстанавливают иммунную систему организма и превращаются в клетки, перед которыми не стоит задача разрушения нервной системы.
Несмотря на то что эта процедура признана эффективной, через несколько лет возможен рецидив заболевания.
Клинические исследования трансплантации стволовых клеток при РС
Метод лечения рассеянного склероза с помощью трансплантации стволовых клеток достаточно нов. Небольшие клинические исследования трансплантации стволовых клеток больным рассеянным склерозом были проведены в Европе, Соединенных Штатах и России. В этих исследованиях изучались преимущества трансплантации гемопоэтических (клетки, из которых затем формируются различные клетки крови) стволовых клеток, полученных из костного мозга или крови участников, т.е. аутотрансплантации стволовых клеток взрослого организма.
Эти исследования были начаты после того, как было замечено, что у нескольких пациентов, больных РС, у которых развилась лейкемия (рак крови), лечение рака с помощью стволовых клеток, привело к улучшениям со стороны нервной системы. Ученые предположили, что если путем химиотерапии и облучения ликвидировать аутоагрессивные клетки (такие как Т-лимфоциты), которые повреждают миелин, а потом путем трансплантации стволовых клеток «вырастить» новый, не аутоагрессивный (ауторезистентный) клон этих клеток, то в дальнейшем можно ожидать приостановление патологических процессов демиелинизации.
С 1995 года в рамках клинических исследований (КИ) были проведены трансплантации собственных стволовых клеток более чем 200-м больным рассеянным склерозом. Поскольку в этих исследованиях участвовало немного больных рассеянным склерозом, эти исследования были классифицированы как I/II фаза КИ. Во всех этих исследованиях участники прошли интенсивную химиотерапию с целью подавления иммунной системы в течение недели до «пересадки» стволовых клеток.
Ниже приведены опубликованные результаты некоторых клинических исследований:
Европейская группа по трансплантации костного мозга (EBMT)
В 2002 году Европейская группа по трансплантации костного мозга провела всесторонний анализ данных о 85 пациентах, больных рассеянным склерозом, которым была проведена трансплантация стволовых клеток . Поскольку учеными анализировались результаты различных исследований, методы подавления иммунной системы, реинфузии стволовых клеток не были одинаковым для всех 85 человек.
Анализ показал, что трансплантация гемопоэтических стволовых клеток является потенциально эффективным методом лечения некоторых больных рассеянным склерозом. По данным МРТ у большинства пациентов отсутствовала активность РС. Менее однозначным было влияние трансплантации на стабилизацию симптоматики и клиническое прогрессирование заболевания. Ученые отметили, что процедура пересадки СК связана с 5% риском смертности.
Итальянская группа по трансплантации костного мозга
В декабре 2005 года были опубликованы результаты II фазы клинического исследования проведенного итальянскими учеными. В этом исследовании принял участие 21 больной РС, которые начали испытывать трудности при ходьбе (EDSS 5,0-6,5), состояние которых быстро ухудшалось и они не реагировали на стандартное лечение рассеянного склероза. После трансплантации состояние 20 человек стабилизировалось или улучшилось. Состояние одного участника также улучшилось на начальном этапе, однако стало ухудшаться через девять месяцев после процедуры.
Голландия, медицинский центр Erasmus
В январе 2006 года группа специалистов из Голландии сообщила о результатах аутотрансплантации стволовых клеток у 14 пациентов с рассеянным склерозом (EDSS 5,0-6,5). На протяжении 36 месяцев после трансплантации состояние трех пациентов стабилизировалось, двух — улучшилось. Однако, состояние девяти пациентов ухудшилось, шесть утратили способность ходить.
США, Чикаго, отделение иммунотерапии Университета Northwestern
В этом исследовании принимали участие 21 человек с рецидивирующе-ремиттирующим РС, у которых, несмотря на лечение бета-интерфероном, в течение года, предшествующего трансплантации, было два и более рецидива. После трансплантации ученые наблюдали за состоянием этих пациентов в течение трех лет. В соответствии с оценкой по шкале EDSS, состояние всех участников не ухудшилось, состояние 17 больных улучшилось, по крайней мере на один балл. У 16 человек после лечения стволовыми клетками не было отмечено клинических рецидивов.
Россия
В России операции по пересадке стволовых клеток проводятся в Главном военном клиническом госпитале имени академика Н.Н.Бурденко в Москве , в Военно-Медицинской Академии в Санкт-Петербурге, в Институте клинической иммунологии в Новосибирске, в Санкт-Петербургском государственном медицинском университете имени академика И.П. Павлова
Симптомы рассеянного склероза у мужчин и женщин
Проявления РС очень многообразны и зависят от того, в каком участке мозга возникают бляшки. Более того, симптомы могут возникать и исчезать, что существенно осложняет диагностику.
С течением болезни первые признаки рассеянного склероза становятся все более выраженными, к ним добавляются новые симптомы, состояние функциональных систем в целом значительно ухудшается. Возможны, но далеко не обязательны, следующие проявления:
- зрение может снижаться до 0,1 и менее, часто один глаз видит лучше другого;
- речевая функция постепенно нарушается — от легкой путанности и затрудненности речи до невозможности разговаривать и глотать;
- мышечная сила постепенно снижается вплоть до полной неподвижности;
- первичные незначительные нарушения координации могут перейти в полную невозможность нормальных направленных движений;
- чувствительность тела может исчезнуть на всем теле, кроме головы;
- интеллектуальные способности снижаются, в крайних стадиях возникает деменция;
- при сильном поражении тазовых органов наблюдается недержание мочи и кала.
https://youtube.com/watch?v=GYxNqUhLcmU
Конечно, перечисленные крайние степени нарушений возникают при очень длительном течении болезни либо при отсутствии или низком качестве лечения. Своевременная диагностика рассеянного склероза на ранней стадии и правильная терапия помогают пациентам прожить всю жизнь без значительной степени инвалидизации.
Основные терапевтические методы
Эффективность процедуры зависит от тяжести и запущенности заболевания. Врачи, практикующие такой способ терапии, предупреждают, что лучше начинать лечение как можно раньше.
https://youtube.com/watch?v=I3tBWpnpB5w
В таком случае иммунная система не успевает поразить большое количество нервной ткани в головном мозге и проводящих путях.
Судя по отзывам о применении стволовых клеток при рассеянном склерозе, у некоторых больных пропадало дрожание рук, останавливалось прогрессирование заболевания, но инвалидность сохранялась.
Как применяют Авонекс от рассеянного склероза: показания, противопоказания
Важно узнать, как помогает Нейромидин в уколах при рассеянном склерозе: кому показан, как использовать, аналоги
Все о симптомах и лечении демиелинизирующих заболеваний головного мозга у больных различного возраста.
Заключение
В протоколе ведения больных терапия подразделяется на два направления, одно из которых непосредственно устраняет обострение, другое призвано тормозить процесс развития недуга.
Внимание. Если заболевание не лечить, то прогноз будет неблагоприятным и спустя некоторое время можно стать инвалидом
Статистика показывает, что это состояние может развиться как в течение трех лет, так и тридцати.
Медикаментозная схема, как бороться с недугом
При обострении заболевания, согласно клиническим рекомендациям, доктор назначает пациенту гормональные препараты (глюкокортикостероиды).
Больному колют Метилпреднизолин (в количестве 1-2 г на пять или шесть суток) или Преднизолон (1,5 мг на один кг общей массы тела).
Общий курс гормональной терапии длится в среднем до шести недель.

Альтернативой иммуномодуляторов являются цитостатики. Данные лекарства направлены на снижение активности иммунитета, к ним относятся Азатиоприн, Циклофосфамид.
Для устранения симптомов и облегчения состояния больного применяются другие лекарственные средства:
- Церебролизин, Глицин, Глутаминовая кислота, витамины группы В (принимаются курсами для нормализации состояния нервной системы).
- Мидокалм, Сирдалуд (препараты для снижения тонуса в мышцах).
- Финлепсин, Антелепсин (лекарства для устранения судорог).
- Феназепам, Сибазон (медикаменты для уменьшения тремора и устранения невротических симптомов).
- Прозерин, Галантамин (препараты при расстройствах мочеиспускания).
- Пароксетин, Флуоксетин (лекарства для устранения депрессивных расстройств).
Уколы и прививки
Аутовакцинация основана на выделении лейкоцитов у пациента и их искусственном стимулировании клетками нервной системы. В результате такой стимуляции в организме больного должны начать размножаться Т-лимфоциты, которые подвергаются воздействию радиации и снова вводятся в организм пациента.
Реакция организма такова, что он начинает уничтожать чужеродные тела, заодно расправляясь со здоровыми Т-лимфоцитами. Эффективность метода пока не подтверждена.
Как победить недуг с помощью стволовых клеток?
Метод был разработан в 2003 году. В его основу легли такие полезные свойства клеток, как возможность устранения ими рубцовых тканей и восстановления миелиновых волокон.
При лечении этим способом у больного изымается биоматериал, из него выделяются стволовые клетки, которые выращивают в условиях лаборатории, а затем снова вводят пациенту.
Пункция
Важно! Процедура пункции применяется для диагностики заболевания. Этот метод направлен на анализ ликвора, повышенное количество антител в нем указывает на болезнь

Сам процесс взятия пункции длится не более 10-15 минут, проходит при обезболивании. Спинномозговая жидкость берется на исследование в количестве 5-10 мл.
Пересадка костного мозга
Трансплантация костного мозга является одним из самых эффективных методов лечения. Процедура пересадки довольно сложная, перед ее проведением пациент проходит химиотерапию, затем ему пересаживаются изъятые из кости клетки костного мозга.
Лампа для обследования
Существует несколько способов диагностики заболевания. Одним из самых оптимальных обследований является МРТ головного и спинного мозга. С помощью этого исследования можно точно определить локализацию и размеры склеротических очагов.
Успешно проходит диагностика недуга с применением суперпозиционного электромагнитного сканирования. Метод позволяет определить суммарную и очаговую потерю миелина, установить состояние ионного обмена в тканях и активность нейромедиаторов.
Агрессивное воздействие на клетки посредством химиотерапии не дает ощутимых результатов. Ни один пациент при этом полностью не излечился.
-
Процедура удаления лазером образования или родинки сопровождается испарением их клеток до полного выравнивания поверхности кожи. Луч лазера полностью контролируем, поэтому соседние участки ткани не успевают нагреться и не происходит их ожога.
-
Лазерная коагуляция вен — заваривание вены лазером при варикозной болезни.
-
Лазерная облитерация вен — безразрезный метод закрытия просвета вены под действием лазерного излучения.
-
Хирургическое удаление варикозно расширенных вен с наложением косметических швов применяется в запущенных случаях.
-
Лечение больных наркоманией проводится только в учреждениях государственной и муниципальной систем здравоохранения. Наиболее эффективным является тот вариант, когда больной наркоманией сам осознает свою болезнь и ощущает потребность в излечении.
Возможные риски лечения стволовыми клетками
Многообещающий потенциал результативного лечения стволовыми клетками уравновешивается рисками, которые ученым еще предстоит оценить и преодолеть. К ним относятся:
Нежелательное развитие клеток
Для трансплантации необходимо большое количество клеток. Например, эмбриональные стволовые клетки легко могут быть выращены в лабораторных условиях, однако специалистами на сегодняшний день не преодолен риск неконтролируемого развития этих клеток и возможного роста различных опухолей. Кроме того, трансплантация эмбриональных стволовых клеток, всегда будет аллогенной трансплантацией (см. ниже), следовательно, велик риск отторжения этих клеток.
Поэтому терапия эмбриональными стволовыми клетками в настоящее время не применяется. Стволовые клетки в тканях взрослого человека встречаются редко и методы их успешного выращивания в лабораторных условиях пока не разработаны.
Иммунное отторжение
Существует два основных вида трансплантации стволовых клеток:
- аутологичная трансплантация — реципиент получает собственные стволовые клетки;
- аллогенная трансплантация — реципиент получает стволовые клетки от донора.
При аутотрансплантации клетки не будут отторгнуты, т.к. иммунная система человека получает при трансплантации свои собственные клетки. Тем не менее, при аллогенной трансплантации существует риск иммунного отторжения, т.к. иммунная система будет воспринимать эти клетки как «чужеродные» и бороться с ними.
Подавление иммунной системы до трансплантации
Обычно перед трансплантацией, с помощью химиотерапевтических препаратов, подавляется собственная иммунная система пациента. Используемые препараты, как правило, очень токсичны для организма.
В целом, специалисты сходятся во мнении, что для того, чтобы лечение стволовыми клетками, вошло в привычную практику, понадобится еще не один год. Остается еще достаточное количество проблем и вопросов, решение которых, еще предстоит найти, в частности ученым еще предстоит научиться:
- выращивать достаточное для трансплантации количество стволовых клеток ;
- успешно контролировать, превращение стволовых клеток в требуемый тип клеток;
- контролировать и влиять на процессы интеграции пересаженных клеток, их выживаемость и процессы «целевой доставки» к поврежденным тканям и органам;
- сводить к минимуму нежелательные побочные эффекты и риски.
Вопрос-ответ
Сколько стоит лечение рассеянного склероза стволовыми клетками?
Средняя цена на лечение рассеянного склероза стволовыми клетками составляет 26 000 $, минимальная — 25 000 $, максимальная — 27 000 $. Данные подтверждены Bookimed. Информация основана на запросах пациентов и официальных расценках от 17 клиник по всему миру.
Кому нельзя стволовые клетки?
Стволовые клетки не рекомендуется применять людям с активными инфекциями, злокачественными опухолями, аутоиммунными заболеваниями, а также тем, кто принимает иммуносупрессивные препараты или имеет серьезные нарушения в работе органов и систем, таких как печень или почки. Кроме того, противопоказания могут включать беременность и индивидуальную непереносимость компонентов, используемых в терапии.
Советы
СОВЕТ №1
Перед принятием решения о лечении рассеянного склероза стволовыми клетками, обязательно проконсультируйтесь с опытным неврологом или специалистом в области клеточной терапии. Они помогут вам оценить все риски и преимущества данного метода, а также предложат альтернативные варианты лечения.
СОВЕТ №2
Изучите клиники и медицинские учреждения, предлагающие лечение стволовыми клетками. Обратите внимание на их репутацию, лицензии и отзывы пациентов. Это поможет вам выбрать надежное место для проведения процедуры.
СОВЕТ №3
Подготовьтесь к возможным побочным эффектам и осложнениям, связанным с лечением стволовыми клетками. Обсудите с врачом, какие меры предосторожности следует принять и как можно минимизировать риски.
СОВЕТ №4
Не забывайте о комплексном подходе к лечению рассеянного склероза. Стволовые клетки могут быть частью вашей терапии, но важно также учитывать медикаментозное лечение, физиотерапию и изменения в образе жизни для достижения наилучших результатов.